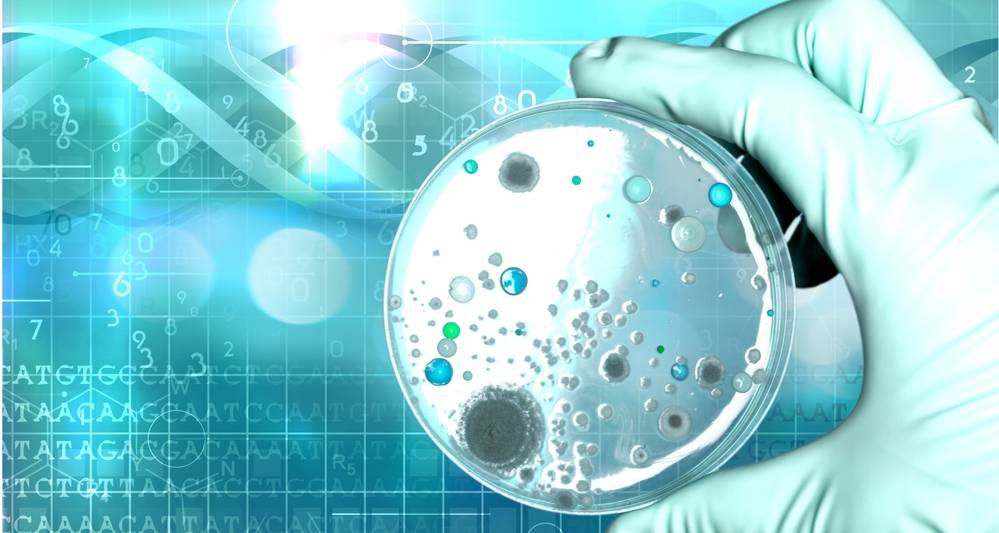

Как заботиться о микробиоме
На сегодняшний день самый простой и доступный способ заботиться о микрофлоре кишечника — придерживаться здорового образа жизни и, как бы банально это ни звучало, прислушиваться к организму. Например, известно, что повышенное потребление сахара действительно может негативно влиять на микрофлору и способствовать активному размножению грибков Candida в организме. Но одним для этого достаточно кусочка торта, а другие не испытают проблем и от коробки пирожных, запитых фантой. Здоровый человек может отслеживать своё состояние после приёмов пищи, отмечая, на какие продукты организм реагирует особенно чувствительно. Но, конечно, при появлении проблем не стоит заниматься самолечением — нужно обратиться к терапевту или гастроэнтерологу.
В целом рекомендации по «уходу за микробиомом» для всех общие и на удивление совпадают с рекомендациями для поддержания здоровья в целом: есть побольше богатых клетчаткой овощей и злаков, не злоупотреблять сахаром, пить достаточно воды, хорошо спать и регулярно двигаться. А ещё с помощью еды можно улучшить себе настроение и бороться со стрессом — и речь здесь не о еде вроде мороженого, а о продуктах, которые помогают бактериям вырабатывать нейроактивные вещества и положительно влиять на работу нервной системы. В полезном списке всё те же богатые антиоксидантами ягоды и фрукты, насыщенный триптофаном сыр и бананы, орехи и рыба с высоким содержанием жирных кислот омега-3.
ФОТОГРАФИИ: science photo — stock.adobe.com, Andrii Zastrozhnov — stock.adobe.com
Что такое микробиом кожи и как образуется
Кожа человека стерильна, то есть лишена бактерий, вирусов и грибков только до рождения. Во время естественных родов она заселяется бактериями половых путей матери. Когда родоразрешение осуществляется путем кесарева сечения , она заселяется в первую очередь бактериями с кожи матери или – что определенно менее благоприятным вариантом – микроорганизмами, живущими в операционной.
Состав и количество микроорганизмов, обитающих на коже, эволюционируют с возрастом хозяина. Это происходит не везде одинаково. У каждого вида микроорганизмов есть своя ниша, то есть участок на коже, который заселяется крайне охотно из-за специфических условий, которые там преобладают, то есть влажности, доступа света.

Некоторые штаммы бактерий особенно любят места, где образуется кожный жир, другие выбирают участки с хорошо увлажненной кожей, а третьи предпочитают сухие участки. Микроорганизмы населяют не только верхний слой кожи, то есть эпидермис, но и сальные железы и волосяные фолликулы дермы.
Связь между микробиомами и здоровьем
Чем больше ученые узнают о микробиоме, тем больше получают доказательств, что дисбаланс микроорганизмов может быть как причиной возникновения болезни, так и причиной восстановления здоровья.
Существуют тесные связи между микробиомом кишечника и возникновением таких болезней как диабет 2 типа, ожирение, ревматоидный артрит, цирроз, воспалительные заболевания кишечника, метаболический синдром. Кроме того, ученые предполагают наличие взаимосвязи между кишечным микробиомом и склонностью человека к тревогам, депрессии и аутизму.
Пищеварение и питание
Микробиота – ключевой фактор, влияющий на пищеварение. Без кишечной микрофлоры многие популярные продукты, которые употребляет человек, были бы для него несъедобными. Например, ту же клетчатку, содержащуюся в овощах, фруктах и орехах организм не способен усвоить без кишечного микробиома.
В желудочно-кишечном тракте человека легко расщепляются моносахариды (глюкоза) и дисахариды (лактоза). Но ему гораздо труднее переваривать сложные молекулы и полисахариды, а это белки, жиры, крахмал и другие сложные углеводы, полученные из овощей и мяса. И вот здесь на помощь приходит кишечная микробиота, бактерии которые расщепляются путем ферментации сложные составы до метаболитов, которые организм уже способен усвоить и использовать в собственных потребностях.
На протяжении множества лет человечество было убеждено, что масса тела определяется исключительно тем, сколько человек употребляет пищи. Но недавние экспериментальные исследования на мышах продемонстрировали, что на склонность к полноте влияют микробы, живущие в наших телах. После пересадки подопытным животным микробиоты из кишечника худощавого и тучного человека, мыши, которым достались микробы от более упитанного человека, набрали лишний вес. Вопрос, работает ли эта схема и с человеческим организмом, требует дальнейшего изучения. Но если это так, то микробиота может стать лекарством против ожирения.
Иммунитет и воспаления
Доказано, что от баланса кишечных микробов во многом зависит и баланс иммунной системы. В человеческом кишечнике содержится больше иммунных клеток, чем в любом другом участке организма. То есть микробиота кишечника и клетки иммунитета пребывают в постоянном контакте. Если эту взаимосвязь нарушить, появляется риск развития сложных заболеваний, включая аллергию, ожирение, диабет, депрессию и даже рак.
Экспериментальные исследования на мышах, кишечник которых был максимально “стерильным” продемонстрировали, что такие животные были очень болезненными, у них появились симптомы воспаления легких, астмы и воспалительных заболеваний кишечника. После подсадки мышам бактерий от здоровых животных, они быстро восстанавливались, однако состояние улучшилось только у самых маленьких животных (в возрасте 1-2 недель), более взрослым «пересадка» микробиоты не помогла
Результаты эксперимента расцениваются как очередное подтверждение важности микробиома для выживаемости младенцев и укрепления их иммунитета
Кроме того, исследования показали, что нарушение кишечного микробиома повышает риск воспалительных заболеваний, в том числе болезни Крона и целиакии, а также делает человека более склонным к аллергиям.
Головной мозг и нервная система
Лучшие материалы месяца
- Коронавирусы: SARS-CoV-2 (COVID-19)
- Антибиотики для профилактики и лечения COVID-19: на сколько эффективны
- Самые распространенные «офисные» болезни
- Убивает ли водка коронавирус
- Как остаться живым на наших дорогах?
Существует тесная взаимосвязь между желудочно-кишечным трактом и центральной нервной системой. Эта связь базируется на блуждающем нерве, который посылает сигналы из кишечника в мозг и наоборот. Кишечный микробиом способен вырабатывать целый ряд нейротрансмиттеров, в том числе серотонин и ГАМК, которые влияют на настроение, аппетит и мышление, а также могут активировать блуждающий нерв.
В одном из исследований ученые обнаружили, что мыши, которым внедрили штамм кишечной бактерии Lactobacillus rhamnosus, в стрессовых ситуациях проявляли меньше беспокойства и у них вырабатывалось меньше гормона стресса, чем у контрольных животных. При выключении у животных блуждающего нерва различия в поведении мышей исчезли, независимо от состояния их кишечного микробиома.
Другие исследования на мышах также подтвердили существование взаимосвязи между кишечными микробами и депрессией, болезнью Паркинсона, аутизмом, нарушениями настроения. Клиницисты отмечают, что почти 70% детей и подростков, страдающих аутизмом, имеют проблемы с работой желудочно-кишечного тракта, что также может быть свидетельством взаимосвязи между микробиомом и работой головного мозга.
Влияние микробиома кишечника на нашу жизнь
Это общеизвестный факт, что кишечные бактерии критически важны для пищеварительной системы, а также снабжают нас полезными веществами, однако не все знают об их прямом влиянии на наше поведение и настроение. Более того, есть смелые теории, что они также способны влиять на наши вкусовые предпочтения. Имея симбиотическую связь с нами, они выделяют множество химических соединений, которые способны проникать в мозг, а также взаимодействовать с иммунной и гормональными системами.
Микробиом оказывает огромное влияние на наше здоровье. Например, присутствии некоторых патогенных видов или отсутствие полезных микроорганизмов могут приводить к различным неблагоприятным состояниям и болезням. Кроме конкретных заболеваний вызванных тем или иным возбудителем, плохая кишечная микрофлора может способствовать депрессии, аутизму, рассеянному склерозу, сахарному диабету и ожирению.
Но пробежимся по полезным эффектам, которые мы получаем от такого «сожительства».
Пищеварение
Пищеварение — это сложный процесс превращения пищи в питательные вещества, которые наш организм может использовать как материал для строительства новых тканей, поддержания жизнедеятельности старых, а также для производства регулирующих химических соединений, энергии и много другого. Удивительно, но не смотря на миллионы лет нашей эволюции, без микробов, мы не способны полноценно переваривать и усваивать пищу.
Иммунитет
Наука считает, что около 70% нашей иммунной системы происходит из кишечника. Микробы связываются с иммунными клетками и контролируют реакцию организма на инфекции. Они также выделяют вещества, которые делают кишечную и слизистую среды неблагоприятными для патогенных микроорганизмов и грибков.
Здоровье мозга
Новые исследования показывают, что центральная нервная система и кишечный микробиом тесно связаны. Передача сигналов в мозге происходит посредством выделения из синапсов специальных молекул — нейромедиаторов. Наверняка вы слышали о таких нейромедиаторах как серотонин, дофамин, ГАМК, гистамин и норадреналин, которые активируют или тормозят нейроны в мозге и регулируют ваше поведение и настроение.
Так вот, некоторые микробы способны вырабатывать эти нейромедиаторы, но также множество других химических соединений, которые используются организмом для их синтеза.
Контроль уровня сахара в крови
Исследование показало, что менее разнообразные микробиоты кишечника связаны с диабетом первого типа у детей. Было также обнаружено, что некоторые грамотрицательные бактерии были более распространенными непосредственно перед постановкой этого диагноза. Кроме того, постпрандиальный уровень сахара в крови широко варьируется среди населения, даже когда мы потребляем одну и ту же пищу. И это может быть отчасти связано с различиями в кишечных бактериях.
Большинство нейромедиаторов, таких как серотонин и дофамин, находятся в пищеварительном тракте, а не в мозге. Эти два органа общаются друг с другом по оси кишечник-мозг, что очень тесно связывает наше психическое и желудочно-кишечное благополучие. Не только пища, которую мы едим, оказывает глубокое влияние на наше психическое состояние, но и психологический стресс также отрицательно влияет на пищеварение.
Сердечно сосудистая система
Микробиом кишечника играет важную роль в обеспечении оптимального уровня холестерина ЛПВП и триглицеридов. Некоторые штаммы бактерий преобразуют питательные вещества, содержащиеся в красном мясе, в ТМАО (триметиламиноксид), химическое вещество, которое способствует закупорке артерий, что может привести к инфаркту миокарда или инсульту. И наоборот, другие виды, такие как лактобациллы, могут снижать уровень холестерина ЛПНП при приеме в пробиотической форме.
Масса тела
Многие исследования показали связь между дисбактериозом кишечника или неблагоприятным балансом хороших и плохих микробов и ожирением. В экспериментах на грызунах, им имплантировали микробиом от людей с ожирением, и они набирали больше веса, чем те, которые получили бактерии от худощавых людей. Эта закономерность соблюдалась, даже когда у них была одинаковая диета.
Это далеко не исчерпывающий список, но надеюсь, вы получили представление насколько важен кишечный микробиом для всех аспектов нашего здоровья.
Как восстановить микробиом кожи
Поможет здоровый образ жизни.
Сбалансированное питание, то есть достаточное количество белка, «хороших» жиров и углеводов: фруктов, овощей, злаковых.
Как изменить свой образ жизни с пользой для кожи. 11 советов
Ограничение потребления быстрых углеводов. Ничто так не нарушает микробиом кожи, как злоупотребление сладким.
Физическая активность на свежем воздухе — работа в саду, прогулки по лесу, пробежки в парке. Природные микробы-туристы способны изменить микробиом кожи в лучшую сторону.
Жизнь без стрессов. Конечно, это из области фантастики, но в наших силах научиться философски воспринимать неприятные ситуации.
Как стресс влияет на кожу
Здоровый сон. Микробиота чутко реагирует на любые изменения в нашем образе жизни.
Деликатный уход за кожей. «Для очищения выбирайте мягкие средства, которые не разрушают защитный слой кожи: для микроорганизмов, живущих на поверхности, важна среда обитания, — говорит Александр Прокофьев. — Используйте косметические средства, содержащие пребиотики и пробиотики».
Идентифицированные микроорганизмы микробиоты человека
В этой таблице представлен перечень наиболее изученных бактерий (род и виды), населяющих человеческие организмы.
| Род бактерий | Виды | Где живет | Главные функции |
|---|---|---|---|
| Bacteroidetes | B. acidi faciens B. eggerthii B. fragilis B. helcogenes B. intestinalis B. thetaiotaomicron | Кишечник | Вырабатывает метаболиты, которые препятствуют воспалениям |
| Bifidobacterium | B. crudilactis B. denticollis B. gallicum B. gallinarum B. hapali B. indicum B. pullorum B. reuteri | Кишечник, ротовая полость, влагалище | Выполняет ряд полезных для организма функций, в том числе служит для профилактики и лечения язвенного колита |
| Lactobacillus | L. rhamnosus L. casei L. fermentum L. gasseri L. plantarum L. acidophilus и L. ultunensis | Рот, кишечник, влагалище | Профилактика и лечение диареи, а также других нарушений пищеварения |
| Prevotella | P. copri P. dentalis P. maculosa P. marshii P. oralis P. oris P. saliva | Рот | Регулирует метаболические процессы |
| Pseudomonas | P. aeruginosa P. maltophilia P. aeruginosa P. fluorescens P. putida P. cepacia P. stutzeri | Кожа, горло, рот, кишечник, мочеиспускательный канал, влагалище | Вызывает сыпь и кожные инфекции |
| Стрептококк | S. mitis S. salivarius S. mutans S. pneumonia S. pyogenes | Кожа, глаза, нос, горло, рот, кишки, влагалище | Вызывает разные заболевания, включая пневмонию, фарингит, кожные поражения, сепсис |
Исследование микробиомов – сравнительно новое течение в науке. Хотя следует отметить, что русский ученый Илья Мечников еще в 1908 году предположил, что здоровье можно улучшить, а старение организма замедлить, если подкорректировать микрофлору кишечника с помощью полезных бактерий, обнаруженных в кисломолочной продукции. Исследователям предстоит узнать еще много о микробиоте. Но уже есть понимание, что микробы – это не всегда зло и опасность.
Больше свежей и актуальной информации о здоровье на нашем канале в Telegram. Подписывайтесь: https://t.me/foodandhealthru
Автор статьи:
Извозчикова Нина Владиславовна
Специальность: инфекционист, гастроэнтеролог, пульмонолог.
Общий стаж: 35 лет.
Образование: 1975-1982, 1ММИ, сан-гиг, высшая квалификация, врач-инфекционист.
Другие статьи автора
Редактор статьи:
Момот Валентина Яковлевна
Специальность: Онкология.
Место работы: Институт экспериментальной патологии, онкологии и радиобиологии им. Р. Е. Кавецкого НАН Украины.
Все отредактированные статьи редактора
Будем признательны, если воспользуетесь кнопочками:
Могу ли я просто устранить известные триггерные продукты?
Все время появляются новости, рассказывающие, что определенные продукты являются триггерами для состояния здоровья. Однако не может быть универсального подхода к здоровью, и часто пищевая чувствительность является лишь симптомом несбалансированного кишечника. В то время как некоторые люди могут заболеть от определенных продуктов, другие не будут иметь таких же негативных последствий. Некоторые люди плохо реагируют на сахар, глютен или молочные продукты. Другие не испытывают никаких симптомов при их употреблении. Таким образом, тест на кишечные бактерии поможет вам подобрать подходящий вам план питания и диеты.
Ваш микробиом так же уникален, как и отпечаток пальца. У всех нас есть разные уровни бактерий в нашем организме с нашим собственным уникальным дисбалансом
По этой причине важно разработать план питания, который учитывает собственные уникальные уровни. Единственный способ по-настоящему узнать уровень собственных кишечных бактерий — это пройти тест на микрофлору
Как только вы сделаете это, вы сможете лучше понять, какие шаги следует предпринять для улучшения здоровья.Хотя открытие микробиома человека является довольно новым, это важное открытие. По результатам теста кишечника, человек узнает как восстановить состояние микрофлоры организма или общее самочувствие в геометрической прогрессии. Если вы страдаете от множества симптомов, стоит пройти тестирование, чтобы выяснить, может ли ваш кишечник быть источником данного состояния. Сделайте сегодня тест на микробиом и почувствуйте разницу.
Микробиомные маркеры
Инфекция паразита была особенно связана с присутствием кишечных бактерий из группы Bacteroidales, которые важны для пищеварения и функционирования иммунной системы. Дополнительная работа показала, что паразитарная инфекция, по-видимому, активирует иммунную систему, перекрывая пути, которые вызывают воспаление.
Хотя еще не ясно, влияют ли паразиты на микробиом или состав микробиома влияет на риск заражения паразитом, эти результаты открывают путь для дальнейших исследований, чтобы ответить на эти вопросы.
Будущие исследования могут, например, посмотреть на изменения в микробиоме с течением времени и объединить эту информацию с более подробными данными о диете.
Доктор Рубель надеется, что в долгосрочной перспективе будет возможно разработать стратегии для модуляции микробиома. Таким образом, ученые могут снизить риск паразитарной инфекции для человека или, по крайней мере, уменьшить вред от нее.
Что такое микробиом кожи
Микробиом, или микрофлора кожи – это совокупность микроорганизмов, которые обитают на ее поверхности, не только уживаясь, но и взаимодействуя с клетками эпидермиса. Законы и принципы этого «сотрудничества» отрегулированы эволюцией. И если раньше специалисты ассоциировали здоровье кожи с ее чуть ли не стерильной чистотой, то сегодня пришли к пониманию, что богатый микробиом, наоборот, защищает нас от множества проблем. Разнообразная экосистема считается более устойчивой.
ВАЖНО ЗНАТЬ: Общее количество микробов в нашем теле и на нем аналогично количеству клеток. Подавляющее количество микроорганизмов находится в кишечнике. Второе место по заселенности ими занимает микробиом кожи человека
В основном, это разные бактерии, но даже на коже совершенно здоровых людей обнаруживаются грибки, вирусы и клещи
Второе место по заселенности ими занимает микробиом кожи человека. В основном, это разные бактерии, но даже на коже совершенно здоровых людей обнаруживаются грибки, вирусы и клещи.
Различные микроорганизмы на коже классифицируются, в зависимости от их влияния на человека:
Комменсалы – «дружелюбные» микробы, которые обычно не вызывают каких-либо побочных эффектов.
Симбионты – микробы, полезные для хозяина.
Патогены – болезнетворные микробы.
Большинство микроорганизмов на коже – это комменсалы. Они могут предотвратить колонизацию патогенами. Для этого комменсалы используют источники питания, необходимые вредным микробам для выживания, и производят токсичные вещества, которые препятствуют прилипанию болезнетворных микроорганизмов к клеткам кожи.
Микробы могут вызывать различные инфекционные и неинфекционные заболевания эпидермиса, дермы, подкожной ткани и волосяных фолликулов. Это могут быть и совершенно безопасные инфекции, и потенциально опасные для жизни.
Патогенность инфекции повышают следующие факторы:
Нарушение кожного барьера – например, из-за дерматита или в результате использования медицинского инструмента;
Применение иммунодепрессантов;
Онкологические заболевания;
Вирус иммунодефицита человека;
Очень юный или, наоборот, преклонный возраст;
Генетические причины.
Постоянно присутствующие в определенной части организма человека микроорганизмы называются резидентной микробиотой. Она находится в верхних слоях эпидермиса, в волосяных фолликулах и вокруг них.
К резидентной микробиоте относятся:
Стафилококк;
Микрококк;
Коринебактерии;
Бревитбактерии;
Дермабактер;
Малассезия.
Микробиом кожи со временем, безусловно, меняется качественно и количественно, особенно из-за современного образа жизни. Большинство кожных проблем (от угрей до экземы) связаны именно с нарушением баланса микробиоты.
И снова дисбактериоз
В российской педиатрической практике до сих пор можно встретить диагноз «дисбактериоз», хотя в официальных международных классификациях болезней, например МКБ-10, такого заболевания не существует. В случае диареи или других кишечных проблем у ребенка берут кал на посев, бактериологическая лаборатория подсчитывает количество 20–30 микроорганизмов (бифидо-, лакто-, актинобактерий и др.). Главной целью этих анализов является установление наличия воспалительного синдрома в кишечнике. Но бывают случаи, когда анализ четко показывает дисбактериоз, а человек чувствует себя нормально, никаких клинических симптомов нет, и наоборот.

Само слово «дисбактериоз» не совсем правильное. Речь идет скорее о дисбалансе, который касается не столько количественных характеристик бактерий, сколько большого числа метаболических параметров, включая содержание в кале коротких жирных кислот, индолов, свободной ДНК человека (если есть диарея, т. е. воспалительный синдром, кишечный эпителий активно слущивается). И дисбаланс проявляется не только внутри кишечника, как раньше думали, — это системное заболевание.
Дисбаланс кишечной флоры связан с развитием онкологических заболеваний, различных форм воспалительных процессов, а также с инфекцией клостридиями (эти бактерии часто присутствуют в кишечнике в небольшом количестве, обычно не вызывая патологии). Как правило, клостридиальная инфекция является психогенной; этих тяжелых пациентов долго и массированно лечат антибактериальными средствами.

Когда увлекались секвенированием генов и поиском бактериальных ассоциаций, выяснилось, что с кишечной микробиотой каким-то образом связаны очень многие, самые разные болезни. Среди них — метаболический синдром, диабет 2-го типа, астма, аутизм. Известно, что подсадка мышам микробиоты пациента с аутизмом приводит к формированию сходного синдрома, который снимается пересадкой микробиоты здоровых доноров.
Из чего состоит микробиом
Несколько лет назад на фоне всплеска интереса к теме вместо привычного понятия микрофлоры стали всё чаще звучать более современные термины: микробиом и микробиота. «Микробиом — это экосистема, в которой живут микроорганизмы и ресурсами которой они пользуются. Есть микробиом почвы, океана и других природных ниш. У человека тоже есть разные микробиомы — кожи, кишечника, дыхательных путей и мочеполового тракта. А микробиотой, или микрофлорой, называют сами организмы (бактерии, грибы, вирусы, археи и другие простейшие), которые можно выделить из этой экосистемы и изучить», — объясняет Елена Ильина, доктор биологических наук, руководитель отдела молекулярной биологии и генетики Федерального научно-клинического центра физико-химической медицины ФМБА России. Тем не менее часто термины «микробиом» и «микробиота» используют как синонимы.
Главным стимулом к новым исследованиям микробиоты в начале XXI века стало развитие геномного секвенирования — метода, позволяющего прочитать геном того или иного организма. Чем доступнее и точнее становилась это технология, тем больше микробиологов использовали её в своих исследованиях. Постепенно представление о составе микрофлоры человека изменилось — оказалось, она намного разнообразнее и таинственнее, чем думали раньше. Например, генов бактерий в нашем организме нашлось в 150 раз больше, чем наших собственных. В этом смысле человека можно считать суперорганизмом — не одним, а целой группой синергически взаимодействующих живых существ. Этот термин упоминается в книге американского биолога Родни Дитерта, сформулировавшего идею, что мы не только люди, но и микробы.
При этом состав микробиоты разных людей сильно различается — он зависит от образа жизни, факторов окружающей среды, питания и множества других аспектов, начиная с момента рождения человека. Этому феномену было посвящено большое европейское исследование, результаты которого опубликовали в журнале Nature в 2011 году — тогда учёные впервые выделили так называемые энтеротипы городских жителей со всей планеты. Оказалось, что у разных людей, независимо от континента и страны проживания, в кишечнике превалируют разные группы бактерий — например, бактероиды, руминококки и другие — и всё это разнообразие можно считать вариантами нормы. Но сегодня, спустя всего восемь лет после открытия, к энтеротипам обращаются всё реже — потому что накопился новый огромный массив данных, говорящий о ещё большем разнообразии микробиомов и их эффектов.
Распространенность микробиомов
Микробиом океанов
Океаны покрывают почти 70% нашей планеты, поэтому постоянно проводятся исследования микроорганизмов, населяющих водные пространства. Эти крошечные “жители” являются «строительным материалом» для более крупных форм жизни на планете, они производят почти половину кислорода, которым мы дышим, перерабатывают примерно такой же процент углекислого газа и удаляют больше чем половину метана в мировых океанах.
Микробиом почвы
Почву и ископаемые населяют огромное количество микроорганизмов. По приблизительным подсчетам в каждом грамме почвы содержится около 40 тысяч видов микроскопических обитателей. Они необходимы для поддержки множества процессов, обеспечивающих рост растительности. Также микробиом пчвы отвечает за расщепление загрязняющих среду веществ, за круговорот азота и углерода.
Микробиом атмосферы
Известно, что в атмосфере микроорганизмы присутствуют повсюду, но варьируют от места к месту, а также с течением времени. Микроорганизмы с частичками пыли мигрируют свободно вокруг земного шара. Микробиом атмосферы может влиять на распространение инфекционных заболеваний, общее здоровье людей, сельское хозяйство, формирование облаков и осадков.
Микробиом человека
Согласно данным Национального института здоровья США только 10% клеток, входящих в состав организма человека, являются собственно человеческими клетками, а остальные 90% принадлежат бактериям, населяющим различные микробиоты человека. Таким образом, homo sapiens является «суперорганизмом», в котором сосуществует большое количество различных организмов. В 2008 г. был запущен глобальный проект «Микробиом человека», ставивший своей целью расшифровку генома бактерий, населяющих организм человека. Расшифровкой генома бактерий, населяющих ЖКТ, занимается Европейский консорциум MetaHIT. Уже расшифровано около 3 млн генов, что примерно в 150 раз больше набора генов человека.
Результаты проекта позволят установить взаимосвязь этих генов с состоянием здоровья человека, развитием заболеваний и фенотипом.. По мнению журнала Science, расшифровка метагенома человека входит в число величайших научных открытий последнего десятилетия.
Микробиом человека включает около тысячи разновидностей бактерий, живущих на коже человека, во рту, в его кишечнике и влагалище.
На разных участках тела колонии микробов отличаются друг от друга. Различия между микробиомом кишечника и ротовой полости сравнимы с различием колоний бактерий, обнаруженных на почве и в океанах.
Особенность микробиома каждого человека в его уникальности. Предполагается, что на формирование индивидуального микробиома влияют такие факторы как особенности питания, окружающая среда, генетические факторы и воздействие микробов на человека в самом раннем возрасте. Следовательно, наличие определенного микробиота позволит прогнозировать особенности обмена веществ и указывать на предрасположенность к определенным заболеваниям.
Отмечается, что у лиц с серьезными хроническими заболеваниями, например, с диабетом, разнообразие микробиома упрощается. Также снижение разнообразия микроорганизмов наблюдается у пациентов с дисфункцией кишечника, при аутоиммунных болезнях, ожирении, заболеваниях сердца, а также у лиц пожилого возраста. Это обусловлено тем, что нормальная микробиота кишечника участвует в разнообразных физиологических функциях организма: защитной, пищеварительной, детоксикационной и антиканцерогенной, синтетической, генетической, иммуногенной, в регуляции обмена холестерина и оксалатов.
Микробиом: что это
Микробиом – это микроорганизмы, такие как бактерии, археи, грибки и вирусы, которые обитают в определенной экосистеме или в организме.
Микроорганизмы рспространены повсюду, включая человеческое тело, почву, ископаемые, моря, пресные водоемы, атмосферуи и даже в гидротермальных жерлах и подледниковых озерах.
Термин «микробиом» заменил устаревшее определение микрофлора, поскольку “флора” переводится как растительный мир. Он был впервые внедрен в 2001 г. для обозначения объединенных геномов микробиоты. Микробиота – используется для характеристики микробиоценоза отдельных органов и систем. Например, микробиота кишечника, микробиота кожи, микробиота плаценты, микробиота грудного молока и т. д. Благодаря современным научным исследованиям в области генетики ученые смогли идентифицировать и определить количество микроорганизмов, живущих в организме человека. С помощью новейших научных разработок удалось установить, что существует более 1 100 видов микроорганизмов, большинство из которых анаэробы. Доказано, что чем более разнообразны кишечные микроорганизмы, тем лучше здоровье человека, а низкое разнообразие связано с различными заболеваниями. Внедрение молекулярно-генетических технологий в практику микробиологических исследований позволило получить новую информацию о составе и свойствах интестинальной микробиоты у людей разного возраста.
Все микробиомы имеют несколько общих черт но это динамичное сообщество, которое способно меняться в зависимости от разных факторов, будь-то изменения климата, если говорить о группах, населяющих планету, или изменения диеты, если говорить о микробиоме человека. Но в любом случае микробиом всегда тесно связан со своим хозяином.
Лактобациллы от прыщей и АД
Среди пробиотических штаммов с положительным действием на кожу, доказанных в клинических испытаниях, преобладают бактерии типа лактобацилл, то есть лактобациллы.
Сообщается, что Lactobacillus bifidus улучшает состояние кожи пациентов с розацеа и обыкновенными угрями, а Lactobacillus plantarum стимулирует процесс заживления ран.
Исследования показывают, что регулярный прием пробиотиков с лактобациллами снижает частоту атопического дерматита у младенцев из группы риска. В другом исследовании говорится, что кормление младенцев с атопическим дерматитом штаммами Lactobacillus rhamnosus GG и Bifidobacterium lactis BB-12 снижает тяжесть симптомов атопии.

Оказывается, пробиотики могут не только помочь в лечении атопии, но и предотвратить ее. Всемирная организация по аллергии предполагает, что профилактическое использование пробиотиков у беременных, страдающих аллергией, снижает вероятность возникновения аллергии у ребенка. Если давать их младенцам с высоким риском аллергии, можно предотвратить будущую аллергическую экзему.





































